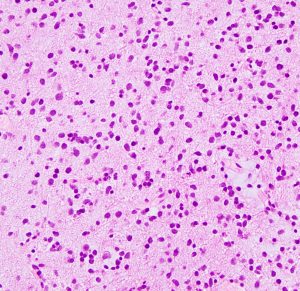

星細胞腫 IDH変異型 astroytoma IDH-mutant WHO grade 2, 3, 4,びまん性星細胞腫 diffuse astrocytoma WHO grade 2
おおまかなこと
- びまん性星細胞腫は,病理組織診断名です
- 2021年からは遺伝子診断となり,星細胞腫IDH変異型とよばれ,グレードが2から4に分類されます
- ほとんどがグレード2です
- 若い成人30歳代にもっとも多いです
- 小児にもみられます
- 初発症状は,てんかん発作が多いのですが,行動異常や人格の変化,言語の障害,軽度の麻痺などの気づかれないような,ゆっくり進行する軽い症状で発症することもあります
- 最近では,MRIで偶然発見される無症状のものも多くなりました
- ほとんどは大脳に発生します
- なぜだか小脳にはできない腫瘍です,小脳にできた場合には毛様細胞性星細胞腫 グレード1を考えます
- ゆっくり増大して,脳の中にしみ込むように広がる (浸潤 infiltration) のが特徴です
- MRI画像でみえるよりも実際はもっと周囲に広がっています
- グレード2から,グレード3やグレード4へ悪性化することがあります
- 逆に,何年も経過を見てもほとんど大きくならないものもあります
- 遺伝子診断すると,IDH1/2とATRX遺伝子変異があります
- しばしば,TP 53の遺伝子変異を伴います
- 組織診断がびまん性星細胞腫グレード2であっても,IDH1遺伝子の変異がないもの(野生型,ワイルドタイプ)では予後不良で,7割程度で膠芽腫という高度悪性腫瘍に相当しますので,グレード2からはずされました
- 逆にIDH変異型で組織像が膠芽腫であれば,IDH-mutant astrocytoma grade 4と呼ばれます
- 注意しなければならないのは,組織がびまん性星細胞腫でIDH野生型でも,毛様細胞性星細胞腫グレード1の部分像をみていることがあります,これをグレード4として治療すると大変なことになります!
- 治療法選択は,腫瘍の進行の程度で決められます,ですから腫瘍が発見されたらまず短期間にMRI検査を繰り返します
- ついに2025年,いままで有効な治療薬がなかった星細胞腫グレード2に,ボラシデニブ vorasidenib(ボラニゴ Voranigo)という経口薬が登場しました ヾ(^▽^)ノ
星細胞腫 2021年WHO分類
もっとも大きな変更点は,組織診断でのびまん性星細胞腫 が 星細胞腫IDH変異型グレード2, 3, 4となり,退形成性星細胞腫の病名が消えたことです。
成人びまん性グリオーマ 2021年分類
Adult-type diffuse gliomas
1. 星細胞腫 IDH変異型 (グレード2): びまん性星細胞腫と言われたものの大部分
Astrocytoma, IDH mutant, nuclear ATRX lost
2. 星細胞腫 IDH変異型 (グレード3): 退形成性星細胞腫のことです
Astrocytoma, IDH mutant, anaplastic histology
3. 星細胞腫 IDH変異型 (グレード4) : CDKNに欠失がある,血管増生や壊死も見られます
Astrocytoma, IDH mutant, CDKN2A/B homozygous deletion
小児タイプのびまん性 低悪性度グリオーマ 2021年分類
Pediatric-type diffuse low-grade gliomas
4. びまん性星細胞腫, MYBあるいはMYBL1 遺伝子異常 (グレード1)
Diffuse astrocytoma, MYB or MYBL1-altered
組織診断でびまん性星細胞腫でも,IDH野生型 wild typeで,TERT promotor mutationもしくはEGFR amplificationもしくは+7/-10 copy number changesがあれば,膠芽腫グレード4 (molecular GBM)と診断しますから,星細胞腫の仲間には入りません
80代の女性に偶然見つかったものです。右の島のグリオーマ insular gliomaで,ガドリニウム増強されないびまん性グリオーマです。右側は2ヶ月半後のMRIで,とても早く広がっていますので,生検術をしました。組織診断は,壊死や微小血管増生はなく,びまん性星細胞腫グレード2でした。TERT promotor mutant, IDH1 WT, IDH2 WT, H3F3A-K27 WT, H3F3A-G34 WT, m HIST1H3B WT, 1p/19q intact, CDKN2A/2B negativeです。
この例は,molecular GBMつまり,glioblastoma IDH-WT WHO grade 4と診断されます。
星細胞腫 グレード2 IDH 変異型
ここから下は,星細胞腫 IDH変異型 グレード2 の記載です
旧来の「びまん性星細胞腫」であり星細胞腫のほとんどを占めます
星細胞腫グレード3と星細胞腫グレード4は別ページを参考に治療を探ってください,この下には記述はありません
注意 : 組織がびまん性星細胞腫でIDH野生型でも,毛様細胞性星細胞腫グレード1の部分像をみていることがあります,これをグレード4として治療すると大変なことになります!
星細胞腫グレード2は治すことができる腫瘍です
びまん性星細胞腫の画像上の3つのタイプ
実際には異なったMRI像を示す3種類のびまん性星細胞腫が知られていました。
1つ目は悪性化もしやすいし生命予後が悪いものです。かなりのものがグレード3/4と同じような臨床像を示します。脳の中心部に発生するものは,病理組織診断ではびまん性星細胞腫なのですがH3 K27遺伝子変異があり、現在は遺伝子診断で びまん性正中グリオーマ グレード4とされるものです。旧来のグリオマトーシスと呼称されたものも含みます。
2つ目と3つ目はゆっくり何年もかけて大きくなるし,手術で治る可能性もあるもので,びまん性星細胞腫といってもかなり性質が違います。古くからIDH-1/2の遺伝子変異がある星細胞腫は限局性で十分な摘出ができる可能性があるとされてきました。
1 脳深部に滲むように広範囲にあり増大速度が速いもの
2 滲むように広がって増大速度がとても「遅い」もの
3 表面にあって境界が明瞭であまり浸潤しないもの
画像所見
- CTでは,低吸収域で周囲の脳より少し黒っぽく見えます
- MRI のT2・FLAIR(フレア)画像で淡く白く見える(高信号)のが特徴です
- 一般的には,びまん性で周囲がはっきりしない脳の中に「にじむような腫瘍」に見えます
- 初期には、一つの脳回に限局して境界が明瞭な小さな腫瘍として発見されることもあります (single gyrus glioma)
- ガドリニウム造影剤で増強されることはほとんどありません
- ガドリニウムで増強された場合はグレード3以上の星細胞系腫瘍が混じっていることを疑います
- 石灰化やのう胞はあり得るのですがとても稀です
- あった場合には乏突起膠腫を疑った方がいいでしょう
- 平均すると年に6mmくらい大きくなります
- でも,ゆっくり大きくなって5年くらい見ていてもあまり大きさが変わらないものから,3ヶ月くらいで倍くらいになってしまうものもあります,油断ができません
- 島 inselを侵す星細胞腫 (insular glioma)は予後不良とされます



左側頭葉のびまん性星細胞腫です。左側のT1強調ガドリニウム像ではほとんど腫瘍は見えません。真ん中のT2強調画像でも見づらいです。右側のフレア画像で白くにじんでいるところに腫瘍があります。どこまでが腫瘍の境界なのかがはっきりしない腫瘍です。左の海馬(記憶の中枢)を侵し,とてもゆっくり大きくなるタイプで,この患者さんは10年以上治療をしないで経過を見ています。全摘出できない星細胞腫グレード2です。
フレア画像です。左上前頭回の星細胞腫ですが,境界がとてもはっきりしていて限局性 localized single gyrus glioma です。びまん性 diffuseには見えません。IDH1の変異があり,1p/19qの欠失はないので星細胞腫グレード2です。上の例とは全く違う臨床像を示しますが,分子病理でも区別はつきません。頑張って早めに全摘出して治してしまった方がいいタイプです。再発を避けるために,supratotal resectionと言って,周囲の正常脳組織も10mmくらい余分に摘出します。
T2-FLAIR mismatch sign (T2とフレアの信号が違うこと)
protoplasmic astrocytomaに特徴的なMRI所見です。T2強調画像(左側)では白く(強い均一な高信号)見えます。でもフレア画像(右側)では白く縁取ったように見えます。びまん性星細胞腫の大きな特徴とされます。内部がとても柔らかいドロドロした腫瘍のこともあります。
mucoid degenerationを含むprotoplasmic astrocytomaの像です。グレード2の典型的病理像です。
重要!見つかったら短期間にMRIを繰り返す
- 病理診断よりも遺伝子診断よりも,MRI画像診断の方が患者さんの予後(命の危なさ)がよくわかります
- 初診で,びまん性星細胞腫を疑ったら,初期には月に一回のMRIをしてもいいでしょう
- 2ヶ月間くらいの短期間に大きくなるものか,それとも数ヶ月くらいでは全く変化ないものかをまずMRIで見極めます
びまん性星細胞腫の病理分類
- 病理診断ではとにかく,IDH1/IDH2遺伝子変異のあるなしを調べなければなりません
- IDH1 codon 132とATRXの免疫染色をして変異があれば診断がつきます
- IDH1 R132H変異はが80-90%ほどですが,他の部位の変異ですと免疫染色では見逃してしまいます
- 必要であれば,IDH2 codon 172 missense mutationをみます (IDH1/2 mutation hotspot sequencing)
- 組織形態学的診断もあわせて整合性を確認します
- 免疫染色でR132が陰性であっても,簡単には野生型 wild typeと決めつけないことも大切です
- ですから,簡単にはwild typeとはいえず,その時にはシークエンスが必要となります
- WHOは,組織診でのびまん性星細胞腫のほとんどにIDH変異があるとしています
- 2021年時点では,IDH野生型であった場合は,多くの場合は膠芽腫 グレード4として治療します
- 野生型で,高度のEGFR増幅,TERTプロモータ変異,第7染色体のゲインと第10染色体の全欠失があればグレード4となるので,膠芽腫と同じ治療をします
- また逆に,IDH変異がなければ,神経節膠腫, 毛様細胞性星細胞腫という良性腫瘍の部分像をみているかもしれません
- 乏突起膠腫との鑑別のために,ATRX遺伝子発現がないことを免疫組織染色で確かめます,ATRX欠損があれば1p/19q染色体を調べなくても星細胞系腫瘍と診断できます
- 2022年時点で,グレード2 星細胞腫ではMGMTメチレーションを検査する臨床的意義はないとされています
- 日本では保険診療でそれを調べることができないから,当分,正確な病理診断は無理!ということになります
- また,文献を調べてもIDH変異のあるびまん性星細胞腫にどのような治療法が選択されるべきなのかは出てきません,臨床研究が追いついていないのです
- 組織診断でgemistocytic variantだけは区別する必要があります
この例では,IDH1 R132Hの変異あり,IDH2の変異はないという解析結果です
治療
- まず治療をするべきかどうかを考えます
- 判断を迷う場合にはMRIを1月ごとくらいに繰り返します
- 数年以上MRIで経過観察できるものがあります
- 診断だけをはっきりさせたい時は,生検術(腫瘍をちょびっと採る)をします
- 治療の目標は「社会復帰ができる」ことです,単なる延命ではありません
- 限局性で完全摘出できるものは,頑張って完全摘出します,それだけで完治することがあります
- 40代より若い患者さんでは,全摘出できれば放射線治療を加えないで経過を見ても良いでしょう
- 欧米の大きな臨床研究では,星細胞腫(グレード2)に対しての放射線治療の有効性(生存期間の延長)ははっきりしませんでしたが,最近では放射線治療が加えられる例が増えています
- 無増悪生存期間(症状が悪くならないで生存できる期間)は延長できると考えられています
- 増大伸展の速いものや手術後に腫瘍が増大したとき(再燃)に50グレイ前後の放射線治療をします
- またさらに,2024年,臨床第3相試験の結果で,初期治療で放射線治療50.4Gyにテモゾロマイドを加えた方が10年生存割合が40%から70%まで上昇すると報告されました。
- 2023年に,ボラシデニブ vorasidenib(飲み薬)の臨床第3相試験の結果が発表され,無増悪生存期間の延長が証明されました,米国で認可され。もうすぐ日本でも使用できるようになるのでしょう
- ですから現段階での一般的な治療は,もしできれば全部摘出する
- 無理しない手術 (maximal-safe resection) で腫瘍が残れば経過観察で様子を見る
- 星細胞腫を60%摘出しても,70%摘出しても,80%摘出しても生命予後は変わりません
- とにかく覚醒下手術を必要以上に行わない
- より多くを摘出した方がいいという”単純 naive” な考え方はできません
- 80%摘出した時点で,あと10%摘出を加えて90%摘出にするために,後遺症(神経脱落症状といいます)を出すリスクを侵すべきではありません
- 残った腫瘍が大きくなりそうな場合、50グレイ前後の放射線治療をします
- 病理診断でMIB-1(Ki67)などで手術で残った腫瘍が明らかに大きくなるのがわかり(強く予想される)ますので,この時には手術後に放射線治療に移ります
- 放射線治療がとても広い領域に必要となる場合には,放射線治療後にゆっくりですが知能(認知機能)の低下が生じることがあります
- なぜ膠芽腫のように60グレイを用いないかというと,もっと低い線量でも星細胞腫グレード2では長期生存が期待できるからです
- 55-60グレイという大きな線量は,かなり高率に脳の機能を落としたり(認知機能低下),脳壊死を生じたりします
- 手術や放射線治療を受ける前に副作用をしっかり聞きましょう
- ボラシデニブの登場で,おそらく化学療法のガイドラインが変わります
- 実際の診療では放射線にテモゾロマイドが併用されることが多いと言えます
- 放射線を加えないテモゾロマイド単独治療では腫瘍の進行を抑えきれません
- 2020年,IDH変異があるびまん性星細胞腫に放射線治療後のPCV化学療法が有効であるとの報告がなされましたが,日本では使用できません
米国FDAが2024年8月にボラシデニブを承認して治療で使用できるようになりました
ボラシデニブの使い方
ボラシデニブを投与すると変異型のIDH1/2遺伝子の働きを抑えて,腫瘍細胞内の2-HGが減少します。そうすると腫瘍細胞お増殖能が低くなって腫瘍増大を抑制します。
臨床の場では,経口投与でボラシデニブ40mgを1日一回服用します。対象は,12歳以上,グレード2の星細胞腫か乏突起膠腫,IDH1/2変異があること,手術後で生検術でも部分摘出でも全摘出でも投与できます。日本では,日本セルヴィエが2024年12月24日、抗がん剤・ボラシデニブクエン酸水和物について、IDH1又はIDH2遺伝子変異陽性の神経膠腫を対象疾患に承認申請しました。
ボラシデニブの副作用(有害事象)

倦怠感,疲労感,頭痛,嘔気,下痢,筋肉痛(骨格筋痛),関節痛,便秘,風邪などの感染症,稀にてんかん発作
血液検査では,ALT, AST, γ-GTP, ALP, ビリルビン上昇,好中球減少です。臓器障害では肝障害がもっとも頻度が高いです。
ひどい倦怠感が日常生活の障害となりますが,体力をなくさない程度に運動して,また大事な仕事のために休憩をとってというバランスが大切になります。
びまん性星細胞腫に対するヨーロッパ EORTCのガイドライン:2017年
- Watch-and-wait 経過観察,ようすを見る
- resection, as feasible 経過を見て必要があると判断すれば,可能な範囲の腫瘍摘出を行う
- radiotherapy followed by PCV 放射線治療とその後のPCV化学療法
- temozolomide plus radiotherapy followed by temozolomide 放射線治療とテモゾロマイド化学療法
エビデンスレベルII,推奨度Bです,術後のfirst-line treatmentとして 3を優先します。日本ではPCVは使えませんからテモゾロマイドとなります。この根拠となったN Eng J Medの論文は,びまん性星細胞腫と乏突起膠腫が混在した母集団を解析したものですから,びまん性星細胞腫グレード2において真実なのかどうかははっきりしません。
限局性の星細胞腫があります
このような表層限局性のタイプが次のWHO分類でどのように位置づけされるのかはわかりません。
無症状で発見された若年成人の星細胞腫 IDH mutant, 1p/19q-intact です。脳の表面にあり,一つの脳回に限局するタイプでsingle gyrus gliomaといいます。 これでもびまん性星細胞腫なのかなと考えてしまうようなものです。迷わずに開頭手術での摘出を勧めました。画像で見えるよりもやや広い範囲の周囲脳摘出 supratotal resectionができた例で,手術後何年か経ちますが幸い再発はありません。
病理は,星細胞に特有の胞体を有しグリア線維が明瞭なびまん性星細胞腫です(クリックすると拡大で見えます)
グリオマトーシスのような星細胞腫があります
軽度の左下肢の麻痺で発症した50代の患者さんです。一見,かつてのグリオマトーシス gliomatosis あるいは diffuse hemispheric glioma WHO grade 4 のように見える非常に広範囲な病変です。しかし,病理診断は 星細胞腫 IDH mutant WHO grade 2でした。

放射線治療によく反応し,片麻痺は消失して,画像上の腫瘍高信号もほぼ消失しています。
予後
- 手術で摘出できるおとなしいびまん性星細胞腫は治癒するので,手術後は普通の人と同じ人生です
- また腫瘍がありながらも手術や放射線治療で20年,30年と暮らしていける患者さんもいます
- 全体としては5年生存割合は70%ほどです
- IDH変異がないと星細胞腫の生命予後は不良で,5年全生存割合は50%以下です
- 短期間に増大傾向がはっきりするもの,6cm以上の大きなもの,脳幹部を侵すもの,中高年のもの,両側大脳半球に及ぶもの,発症時から症状が悪いものなどでは,3年以内に3割くらいの患者さんが死亡します,でもこれらはグレード3か4の星細胞腫です
2020年以前にIDH wild-type 野生型のびまん性星細胞腫とされてきたもの
- 多くは,にじむように淡く広がる腫瘍です
- 膠芽腫グレード4の臨床経過をたどることが多いです
- 特に高齢者では病気の進行は早いです
- しかし,真の膠芽腫グレード4ほどはアグレッシブではないものもあります
- IDH変異がない野生型の予後は悪いので,全て膠芽腫と同じ治療をするという考えは,2023年時点では正しくありません
- 予後がとても良いものもあり,2020年時点で,病理診断ではグレード3か4とされます
- 高度のEGFR増幅,TERTプロモータ変異,第7染色体のゲインと第10染色体の全欠失などがあればグレード4としますが,現実に日本でこれを検査できる施設はほとんどありません
- 一般の施設では,MRIの経過観察が予後を見るための重要な参考データとなります

ここから下は難しくなります
びまん性星細胞腫の手術所見
- 表面にあるものでは,脳が腫れて,脳表が平らになっています (gyrus flattening)
- 色は正常の脳と同じで見分けがつかないことが多いです
- 腫瘍が大きくてコンパクトにある部分では,灰色がかったり少し黄色っぽかったりして正常脳とは異なる色調のことがあり,やや硬く弾性があって粘りがあり,膠(にかわ)腫と呼ばれる腫瘍の特徴を示します
- 黄色透明の液体を含んだ大きなのう胞が見られることがあります
- また,腫瘍のコアの部分では小さなのう胞形成が集簇する部位もあります
- 微小のう胞が多い部分ではゼラチン様に柔らかくなり,吸引器でズルズル吸えます,T2強調画像で強い高信号となっているところは薄い灰色で柔らかくドロドロしています
- 出血は正常脳と同じでほとんどありません
- 石灰化は非常に稀で,砂粒体 psammomaが観察された場合は,乏突起星細胞腫の可能性を考えた方がいいでしょう
- 乏突起星細胞腫は,びまん性星細胞腫よりも放射線化学療法でコントロールできる可能性が高いものですから,それを考慮に入れて摘出の程度を判断します
- 腫瘍を摘出していくと,吸引管バイポーラで触った感じがやや弾性がある firmness, elastic firmもしくは脳より柔らかい softening部分があり,星細胞腫があることが認識できます
- でも,境界に近づくと正常脳と全く区別がつかない触感と色になります。色調は正常でも,「ほんの極わずかな粘りのあるところ」を摘出しきると腫瘍のコアの部分は摘出できています,これが星細胞腫摘出のテクニックの真髄です
- 実際には,腫瘍(脳)の切断面を吸引管でちょっと引っ張ってみます,吸えてこないで粘っと引っ張られるようならそこは腫瘍です
- 正常脳は吸引管のある程度の吸引力で吸えてしまうので,その限界点を指先の感覚として記憶しておくとこの操作ができるようになります
- しかし,深部の正常脳への浸潤境界では,正常脳との識別はまったくできなくなります
- これは病理組織所見を考えれば当たり前のことで,腫瘍細胞 neoplastic astrocytes は,脳の正常構造(神経細胞や軸索)を破壊すること無くもぐりこむように広がっています
- ここは術中MRIにも写らず,ALAでも見えません
- ですから,腫瘍を取りきったと判断してから,可能であればさらに数mmの正常脳と思われる部分の切除を加えます
- 更に摘出を続けることにどれだけの意味があるのかをよくよく考えるところです
星細胞腫グレード2の放射線治療をいつするべきか
- 科学的には答えが出ていません
- そもそもが放射線治療があまり効かない腫瘍です
- 手術で完全摘出できたと判断されれば放射線治療をしません
- 大きくなっていることが明らかな腫瘍で,部分摘出しかできなかった場合は放射線治療をします
- ヨーロッパのガイドラインでは,手術後に残存腫瘍があり,40-45歳以上であれば放射線治療をします,逆にそれ以下の若い年齢では腫瘍が残っていても経過観察することがあります
- 手術後に再発した時や,残った腫瘍が経過を見て大きくなれば放射線治療をします
- 標準的治療法は,50.4グレイを28分割,1日1.8 Gy
- 照射領域の広さによっては,45 – 46グレイを23 – 25分割(1日線量1.8 – 2グレイ)から54グレイを30分割(1日線量1.8グレイ)の範囲で行います
- グレード3は線量を 54Gy に増やしますし,術後にすぐ開始します
ヨーロッパの放射線治療ガイドライン 2025
星細胞腫グレード2と3に対する放射線治療の方針を決めたものです。GTVは,T2/FLAIRで異常に見える部分を全て含みます。ガドリニウム増強される腫瘍は当然含み,手術されていれば摘出腔も囲みます。グレード3で,明らかに脳浮腫と考えられる部分はGTVから外します。CTVは,グレード2で10mm,グレード3で15mmのマージンを取ります。線量は,グレード2で50.4 Gy 28分割,グレード3で59.4 Gy 33分割です。可能な限りIMRTのテクニックを用います。
放射線治療を待機する根拠になった有名な論文
van den Bent MJ, et al.: Long-term efficacy of early versus delayed radiotherapy for low-grade astrocytoma and oligodendroglioma in adults: the EORTC 22845 randomised trial. Lancet 366: 2005
1986年に開始され約20年かかって結論が出されたものです。157人の患者さんが術後早期に54グレイ(一日線量1.8グレイ)の放射線治療を受けました。対して別の157人の患者さんは腫瘍増大などが生じるまで放射線治療が待機されました( wait-and-see)。無増悪生存期間中央値 PFSは,放射線治療を受けると5.3年,待機すると3.4年でした。しかし生存期間中央値は7.4年と7.2年で変わりありませんでした。症候性てんかんのコントロールは早期放射線治療が優ったとのことです。しかし当然ながら,放射線治療による脳機能低下が生じる可能性は早期治療群で早まるはずです。結論として、状態の良い患者さんには放射線治療を延期できるであろうとのことでした。
「解説」正確にはびまん性星細胞腫,乏突起膠腫,乏突起星細胞腫,毛様細胞性星細胞腫が含まれているので,びまん性星細胞腫の治療成績とは言えません。でもこのデータしかないのでこの論文が放射線治療の選択のために今でも引用されます。もう古くなりましたがこの論文を治療の根拠に使用されている脳腫瘍の専門家も多いです。同じ臨床試験を行おうとしても,今後さらに20年以上待たなければ結果は得られません。永遠の命題と言えるでしょう。
旧組織診断病理 astrocytoma grade 2
- fibrirally astrocytoma
- gemistocytic astrocytoma
- protoplasmic astrocytoma
伝統的に上記の3つに分類されてきましたが,2016年に削除されました,全てまとめて組織像としてはびまん性星細胞腫 diffuse astrocytoma です
gemistocytic astrocytoma 肥胖細胞性星細胞腫
gemistocytic astrocytomaは,大きな好酸性の大きな胞体を有する大型の星細胞が多く見られるものをいいます。germistocytesが20%を超えないとこの組織病理診断名は使用しません。
かつて,グレード3あるいはグレード4へ進行(悪性転化)する性質を有しているとされてきました。しかし,これはIDH変異の有無がはっきりしない時期のデータです。2018年時点では,IDH変異があるgemistocytic astrocytomaが,グレード2より悪性度が高いかどうかは不明です。IDH wild-typeは悪性化すると考えたほうがいいので,グレード3に対応する治療方針を選択します。
病理は別のページに詳しくあるのでここをクリック

Ki-67という抗体を使った免疫組織染色でMIB-1 indexというものを見ます。平均で2.5%くらい,高くても4%です。それ以上はグレード3の可能性が高くなります。左の写真のMIB-1の染色率 labling index は3.5%くらいで,グレード2のびまん性星細胞腫としてはやや高い値です。MIB-1染色率が高くなると悪性度が高い傾向にあると考えられます。
びまん性星細胞腫の遺伝子変異
グレード2の乏突起膠腫では第1染色体単腕1pと第19染色体長腕 19qの欠失 (1p/19q codeletion) があることが知られています。グレード2のびまん性星細胞腫では TP53とATRXの変異がみられます。また,IDH (isocitrate dehydrogenase)という遺伝子の異常があると治りやすいあるいは生存期間が長いということも知られてきました。逆に言えば,IDH1の変異が無いびまん性星細胞腫 IDH wild type 野生型では,グレード3やグレード4の星細胞腫のように腫瘍の進行が早くて制御できない可能性が高いということです。さらにかなり前から,IDHの変異のあるグリオーマは手術摘出率が高い(ある意味では浸潤能が低くて限局性)とされてきました。この遺伝子診断も治療の参考になります。
びまん性星細胞腫が悪性化するあるいは急に増大すること
2000年頃の例です。てんかんで発症した20代の女性です。左前頭葉のグリオーマで,手術でほとんどで摘出 subtotal removalして,深部白質に残った病変を経過観察しました。MRIは術後のものです。Ip, 19qはFISHで欠失なし。MIB1は1-2%と低く,MGMTメチレーションなし,diffuse astrocytoma WHO grade 2と組織診断されました。大学病院でしたが当時はIDH遺伝子診断はしておらず,びまん性星細腫グレード2でした。これもまた当時の標準的な考えで,進行があるまでは経過観察としました。
2年後に急激な進行 rapid progressionしました。ガドリニウム増強所見も出現しました。IMRTで59.4Gy/27分割の放射線治療とテモゾロマイド化学療法をしましたが,腫瘍は抑制できませんでした。
放射線治療後も進行して,白質に沿った浸潤伸展をしました。脳幹部橋の右側まで浸潤 invasionしています。この伸展は星細胞系腫瘍の特徴でもあります。
2016年分類では,diffuse astrocytoma WHO grade 2です。しかしこれはおそらく,2021年分類では IDH wild-type astrocytoma grade 4とされます。
びまん性星細胞腫のIDH 野生型 wild type ゆっくり増大するものがあるか?
無症状で発見されたびまん性星細胞腫です。右側はその6年後,非常に緩徐に増大しています。良性のびまん性星細胞腫グレード2を疑い,手術で周囲脳も含めて完全摘出 supratotal resection しました。病理診断は,びまん性星細胞腫 WHO グレード2,MIB-1は2%,1p/19q欠失なしでした。大学病院の病理部ですが当時はIDHの検査をしていません。

術後4年目のものです。深部に小さな再発像が出現しました。これも予想の範囲内でした。これも手術で全摘出しました。普通ならあとは経過観察をするのみです。
しかし,病理診断では IDH1, IDH2ともに変異なし,野生型 wild typeでした。1p/19q non-codel, ATRX mutantです。急速な悪性化が懸念されましたので術後に局所放射線治療を加えました。それ以降は腫瘍再燃はありません。
経過は,IDH mutant diffuse astrocytoma WHO grade 2です。でも,再発像でwild typeでした。malignant transformationなのか?このような例をどう解釈してよいのか不明です。
テント下の星細胞腫
- テント下星細胞腫は,テント上星細胞腫と異なった遺伝子異常を発現していることがあります
- テント上の星細胞の80%以上に一定の位置にIDHの変異があるのに対して,テント下のものは80%が異なった位置に変異 non-canonical IDH mutation を生じています
- ATRXの欠失は50%以下
- MGMTのメチレーションは60%以下にしか認められません
- 放射線治療やテモゾロマイド化学療法の有効性が低い傾向になる遺伝子変異データでもあり,生命予後はテント上のものより不良です
- しかし,脳幹部浸潤を伴うという画像所見から,生命予後不良というのは,遺伝子変異を考えなくても当たり前であるという意見もあります
- しかし一方で,小脳に発生するびまん性星細胞腫は,毛様細胞性星細胞腫に似た,とても良好な予後を示すものがあります
- この毛様細胞性星細胞腫グレード1を星細胞腫グレード2と扱うことには大きな臨床的な注意が必要です,簡単に病理診断を信じない
- 毛様細胞性星細胞腫の組織の一部が,星細胞腫グレード2に類似することがあります
ここからはより専門的な知識
ヨーロッパの放射線治療のガイドライン
Baumert BG: ESTRO-EANO guideline on target delineation and radiotherapy for IDH-mutant WHO CNS grade 2 and 3 diffuse glioma.Radioth Oncol 2025
星細胞腫グレード2と3に対する放射線治療の方針を決めたものです。GTVは,T2/FLAIRで異常に見える部分を全て含みます。ガドリニウム増強される腫瘍は当然含み,手術されていれば摘出腔も囲みます。グレード3で,明らかに脳浮腫と考えられる部分はGTVから外します。CTVは,グレード2で10mm,グレード3で15mmのマージンを取ります。線量は,グレード2で50.4 Gy 28分割,グレード3で59.4 Gy 33分割です。可能な限りIMRTのテクニックを用います。
グレード2グリオーマの放射線治療にテモゾロマイドを併用した方が良い
Schiff D: LTBK-07. PROGRESSION-FREE AND OVERALL SURVIVAL RESULTS OF ECOG-ACRIN E3F05: A PHASE 3 INTERGROUP TRIAL OF RADIATION ± TEMOZOLOMIDE FOR GRADE II GLIOMAS. Neuro Oncol 2024
2024年末のSNOで報告されたとても重要な発表です。臨床第3相無作為E3FO5 trialの継続結果です。172名の低悪性度グリオーマの患者さんを治療後に10年以上経過観察した結果です。初期治療で放射線治療50.4Gyとテモゾロマイドの併用を行なった患者さんでは10年生存割合が70%に対して,併用しなかった群では47%でした。テモゾロマイドの併用がグレード2グリオーマで有効であるという貴重な報告です。もちろん,テモゾロマイドの有害事象や経済的身体的な負担はあるのですが,この生存割合の差はとても大きなものです。
Dr Schiffは重要な結果を含むと続けます。なんと,乏突起膠腫と星細胞腫で生存期間の延長が同程度であったというのです。普通はどう考えても,乏突起膠腫の方がはるかに良い成績のはずですが?
ボラシデニブはてんかん発作の頻度も下げる
Rosa K: Vorasidenib Shows Consistent Efficacy With Manageable Safety in IDH1/2-Mutant Diffuse Glioma. 2024 Nov, SNO, Houston
ボラシデニブ vorasidenib (Voranigo)のINDIGO試験の追加報告です。対象はIDH1/2-mutated diffuse glioma(星細胞腫と乏突起膠腫が入ります)。服用した群でてんかん発作の発症率が低かったそうです。また服用群で腫瘍の体積が減少したのに対し,プラセボ群では腫瘍体積が増大しました。2023年3月の3回目の中間解析では,ボラシデニブ群のPFS中央値はさらに延びてまだ評価できず,プラセボ群では11.4ヶ月でした。明らかな有意差が認められました。
ボラシデニブ vorasidenibは,グレード2の星細胞腫と乏突起膠腫の無増悪生存期間を延長する:臨床第3相試験の結果
Mellinghoff IK: Vorasidenib in IDH1- or IDH2-mutant low-Grade glioma. New Engl J Med 2023
vorasidenibは、変異型IDH1/2酵素の作用を阻害する経口薬で、腫瘍の2-ヒドロキシグルタル酸(2-HG)を90%以上低下させます。経口薬ですが脳内移行がよい薬剤です。術後の残存腫瘍あるいは再燃 168例にvorasidenib (40 mg once daily) が投与されました。観察期間中央値14.2ヶ月の時点で,7割の患者さんがvorasidenibあるいはプラセボを継続服用していました。PFS中央値は,vorasidenibで27.7ヶ月,プラセボで11.1ヶ月でした。グレード3以上の有害事象は22.8%でみられ,ALTの上昇が目立ったそうです。有害事象による中止は3.6%でした。
75%以上摘出すると全生存期間が延びる
Shawn L: Interactive Effects of Molecular, Therapeutic, and Patient Factors on Outcome of Diffuse Low-Grade Glioma. JCO 2023
星細胞腫グレード2と乏突起膠腫グレード2,392例を解析した結果です。結論は,75%以上のEOR(摘出割合)で全生存期間が伸び,80%以上のEORで無増悪生存期間の延長があったとのことです。従来と同様に,神経機能を温存しての最大限の摘出を治療方針とするべきとのことです。逆に,EORが75%に達しない場合はより多くを摘出しても大差はないことになります。星細胞腫では,術後残存腫瘍が4.6ml以上,あるいは術前の腫瘍体積が43.1mlを超えていて術後4.6ml以下のものは全生存期間中央値が短い。乏突起膠腫では,術前の腫瘍体積が43.1mlを超えていても,術後体積が4.6ml以上でも以下でも中間的な生存期間を示しました。生存期間が最も長かったのは,星細胞腫でも乏突起膠腫でも,術前体積が43.1ml以下で,術後体積が4.6ml以下であった場合です。
広範囲摘出 supratotal resection は,IDH変異型グリオーマのFPSとOSをかなり延長する
Rossi M: Association of Supratotal Resection with Progression-Free Survival, Malignant Transformation, and Overall Survival in Lower-Grade Gliomas. Neuro Oncol 2020
319例のIDH変異型グリオーマ(びまん性星細胞腫も乏突起膠腫なども含む)に積極的な摘出術が試みられました。追跡期間中央値は6.8年で190例 (60%)でprogression 再燃が生じました。35%の患者さんでsupratotal resectionができprogressionは6例 (5.4%)でした。一方で,部分摘出や亜全摘出の患者さんでは82%にprogressionが生じました。supratotal resectionの患者さんでは92ヶ月の時点でPFS 94%でした。この結果はIDH以外の遺伝子異常や腫瘍グレードには優位な関連性はなかったとのことです。
PCV化学療法が有効
Comprehensive Genomic Analysis in NRG Oncology/RTOG 9802: A Phase III Trial of Radiation Versus Radiation Plus Procarbazine, Lomustine (CCNU), and Vincristine in High-Risk Low-Grade Glioma. J Clin Oncol 2020
有名なRTOG 9802の追加分析です。グレードIIのグリオーマ106例です。IDH野生型が26例,IDH変異型1p/19q共欠失なし(diffuse astrocytoma)が43例,IDH変異型1p/19共欠失(oligodendroglioma)が37例です。IDH変異型1p/19q共欠失なしとIDH変異型1p/19共欠失で,放射線治療後のPCV化学療法を行なった群で,PFSとOSの有意な延長がありました。IDH野生型では化学療法の有効性はなかったとの結果です。IDH変異型のhigh-risk low-grade gliomaの患者さんはPCV化学療法を受ける価値があると結論しています。
「解説」IDH変異型1p/19q共欠失なしはdiffuse astrocytoma,IDH変異型1p/19共欠失はoligodendrogliomaと捉えることができます。だとすると,従来,化学療法が無効とされたびまん性星細胞腫に放射線後の化学療法が有効となるという,常識をかなり覆す結論です。ここで注意することは,後方視的な解析 multivariable analysesであること,無作為試験ではないこと,例数が43例と少数であることです。また対象となったものは,臨床的にhigh riskと捉えられるグレードIIのびまん性星細胞腫なのです。PCVは2020年時点で,日本では使用できません。
高線量照射に利点はない
Final report from Intergroup NCCTG 86-72-51 (Alliance): a phase III randomized clinical trial of high-dose versus low-dose radiation for adult low-grade glioma. Neuro Oncol 2020
NCCTG-86-72-51の最終報告です。1986年から1994年まで203人のlow-grade glioma (diffuse astroytoma, oilgodendroglioma, oligoastrocytoma) の患者さんが無作為に,50.4Gy (28分割) あるいは 64.8Gy (36分割) の放射線治療を受けました。25年に及ぶ追跡調査の結果です。無増悪生存期間は5.2年,全生存期間は8.4年でした。追跡期間中央値は17.2年で,33人の患者さんが最終観察時点で生存していました。高線量照射は15年全生存割合も無増悪生存割合も改善しませんでした。全生存期間は,腫瘍が5cm未満かつbaseline MMSE27点以上,もしくは全摘出 GTRできた場合に良好でした。無増悪生存期間は,星細胞腫より乏突起膠腫の方が良く,5cm未満,MMSE 27以上,全摘出できた例で良好でした。baseline MMSEが正常であった患者さんでは,7年後に1例 (5%) で有意なMMSEの低下がありました。
「結論」高線量照射に利点はありません。MMSEで見る限り,放射線治療後の認知機能はstable (あまり落ちないとでも訳しましょうか)でした。
グレード2のびまん性星細胞腫にテモゾロマイドを使用すると悪性化する?
Choi S: Temozolomide–associated hypermutation in gliomas. Neuro Oncol. 2018
びまん性星細胞腫は,グレード3の退形成性星細胞腫やグレード4の膠芽腫へと変わることがあります。テモゾロマイドは壊れた遺伝子を修復する作用を抑制するので,遺伝子変異を招きやすいという欠点があります。テモゾロマイドで治療されたIDH mutantのグレード2のびまん性星細胞腫が,多数の遺伝子変異を有するより悪性度の高いグリオーマ hypermutated phenotype へと進行するという疑いがもたれています。メチレーションを確認しないで安易にグレード2 びまん性星細胞腫にテモゾロマイドを使用しないほうが良いという意見につながっています。
MGMTプロモーター・メチレーションを見なければならない時
- 2017年 EANOのガイドラインで,エビデンスクラス1,推奨度Bです。IDH野生型のグレード2と3のグリオーマで,放射線治療とテモゾロマイドを併用する時,あるいはテモゾロマイド単独使用する場合には,メチレーションのある時のみに使用します。
IDH野生型の時にさらに見るべき遺伝子
Brat DJ: cIMPACT-NOW update 3: recommended diagnostic criteria for “Diffuse astrocytic glioma, IDH-wildtype, with molecular features of glioblastoma, WHO grade IV”. Acta Neuropathol. 2018
IDH変異のない IDH wild-type びまん性星細胞系腫瘍で,high level EGFR amplificationがあるか,whole chromosome 7 gain in combination with whole chromosome 10 lossもしくは TERT promoter mutationがあると,グレード4となるとの報告です。
2017年ヨーロッパのガイドライン
Weller M, et al.: European Association for Neuro-Oncology (EANO) guideline on the diagnosis and treatment of adult astrocytic and oligodendroglial gliomas. Lancet Oncol 2017
このページの上の方にだいたい取り入れて書いてあります。
放射線治療の後でPCV化学療法を行う: RTOG 9802の長期成績
Buckner JC, et al: Radiation plus Procarbazine, CCNU, and Vincristine in Low-Grade Glioma. N Engl J Med. 2016
とても権威の高い雑誌に発表された治療成績です。1998年から2002年の間にグレード2のびまん性星細胞腫あるいは乏突起膠腫の251人の患者さんが治療されました。追跡期間中央値 12年という気の遠くなるほどの長い観察結果です。18歳から39歳で生検術あるいは部分摘出 subtotal resectionを受けた患者さん,あるいはどのような手術結果でも40歳以上の患者さんに,放射線治療の後でPCV化学療法が加えられました。放射線単独では全生存期間は7.8年,PCVを加えると13.3年という大きな差が出ました。10年無増悪生存割合は,それぞれ21%と51%です。乏突起膠腫の組織型で無増悪生存も全生存割合も高かったとのことです。この大規模臨床試験は1998年に開始されており,かなりの乏突起膠腫の混在があります。びまん性星細胞腫 1p/19q non-deletedで真であるかどうか,謎のままでしょう。でも乏突起膠腫においては真の結果と言えます。
テモゾロマイドと放射線治療のどちらを選択するか
Baumert BG: Temozolomide chemotherapy versus radiotherapy in high-risk low-grade glioma (EORTC 22033-26033): a randomised, open-label, phase 3 intergroup study. Lancet Oncol, 2016
Reijneveld JC: Health-related quality of life in patients with high-risk low-grade glioma (EORTC 22033-26033): a randomised, open-label, phase 3 intergroup study. Lancet Oncol, 2016
477人のグレードIIグリオーマ (astrocytoma, oligoastrocytoma, or oligodendroglioma)の患者さんを対象とした臨床第3相試験です。治療を行った基準は予後が悪そうに思える例で,40歳以上,進行性病巣,腫瘍サイズが5cm以上,正中を超える病変,神経症状があったという基準です。無作為に,放射線治療 (conformal radiotherapy; up to 50.4 Gy; 28 doses of 1.8 Gy once daily) あるいはテモゾロマイド化学療法 (75 mg/m2 for 21 days, every 28 days, maximum of 12 cycles)がなされました。
PFS 無増悪生存期間は,テモゾロマイド群で39ヶ月,放射線で46ヶ月と有意差はありませんでした。また,生存の質 health-related quality of life (HRQOL)にも差はありませんでした。有害事象は全般的にテモゾロマイド治療群で多いです。
ただし,IDH変異があり1p/19q欠失がないもの(いわゆるびまん性星細胞腫)では放射線治療のPFSがテモゾロマイドよりも長かったということです。IDH変異があり1p/19q欠失があるもの(乏突起膠腫)とIDH変異がないものでは両群の間に差はありませんでした。
高リスク低悪制度グリオーマに,テモゾロマイドの併用で3年生存割合が73%
Phase 2 study of temozolomide-based chemoradiation therapy for high-risk low-grade gliomas: preliminary results of Radiation Therapy Oncology Group 0424. Int J Radiat Oncol Biol Phys 2015
RTOGが予後が悪いと判断されるlow-grade gliomaの治療成績を報告しました。予後悪化因子は,星細胞腫である,40歳以上,両側大脳半球への伸展,6cm以上の大きな腫瘍,PSが2以上という因子の中で3項目以上をみたす129例です。放射線治療とテモゾロマイド 54 Gy in 30 fractions and concurrent and adjuvant TMZの治療がされました。3年全生存割合は73%,3年無増悪生存割合は59%でした。この報告には若干の乏突起膠細胞系腫瘍グレード2が含まれています。
「解説」治りにくいと判断されるびまん性星細胞腫の3年生存割合は7割くらい,手術放射線化学療法をしても6割で再発するということです。
分子診断より画像診断の方が予後が良くわかる
Gozé, C, Imaging growth and isocitrate dehydrogenase 1 mutation are independent predictors for diffuse low-grade gliomas. Neuro Oncol 16, 2014
131人の組織学的低悪性度グリオーマの患者さんの予後解析です。107人にIDH1の変異がありました。画像診断では5.4mm/年の平均増大速度でした。無増悪生存期間 PFSは,
IDH1変異があると予後が良いことが知られています。全体で見ると,悪性進行のないPFSは画像上でゆっくりした増大速度を示したもので149ヶ月,IDH1変異のあったもので100ヶ月です。IDH1の変異の有無に関わらず,画像上で増大速度の遅い低悪性度グリオーマの予後は良いということです。
「解説」IDH1変異がないと膠芽腫の可能性があり,かなり積極的な治療を行うという風潮にあります。しかし,しばらく経過を見ていてMRIでかなりゆっくりしか増大しないものの予後は,分子診断で予想するよりもはるかに良いということです。
IDH変異のある星細胞腫は広範囲伸展が少ない
Qi S, et al.: Isocitrate dehydrogenase mutation is associated with tumor location and magnetic resonance imaging characteristics in astrocytic neoplasms. Oncol Lett 7, 2014
グレード2と3の星細胞腫193例の画像診断とIDH遺伝子解析です。IDH1/2の遺伝子変異を示したものは,単一脳葉に限局し間脳や脳幹部に少なかった,両側大脳にまたがることが少なく,境界が明瞭でMRIでの信号も均一性がありガドリニウム増強像も均一性が高かったとのことです。
IDH変異のないびまん性星細胞腫の予後はとても悪い
Metellus P, Absence of IDH mutation identifies a novel radiologic and molecular subtype of WHO grade II gliomas with dismal prognosis. Acta Neuropathol. 2010
オリゴも含めての解析ですから星細胞腫だけではありません。IDH変異があるもので5年生存割合は93%,IDH変異のないものでは51%ということです。IDH変異のないグレード2グリオーマは,年齢層が高い,島 insulaに発生率が高い,6cmを超えるものが多い,MRIで浸潤性,p53陰性,1p/19欠失がない傾向です。
グレード2のびまん性グリオーマに高線量照射を使っても生存期間は伸びない
Shaw E, et al.: Prospective randomized trial of low- versus high-dose radiation therapy in adults with supratentorial low-grade glioma: initial report of a North Central Cancer Treatment Group/Radiation Therapy Oncology Group/Eastern Cooperative Oncology Group study. J Clin Oncol. 2002
乏突起膠腫を含む203例のグレード2グリオーマに無作為前向き試験が行われました。64.8グレイ/36分割と50.4 グレイ/28分割の2群で治療が行われました。高線量で5年生存割合は64%,低線量で72%となり,線量が低い方が若干5年生存割合が高くなっています。高線量の方が放射線壊死の合併率は高くなりました。
なぜ60グレイを用いないのか
Karim AB, et al.: A randomized trial on dose-response in radiation therapy of low-grade cerebral glioma: European Organization for Research and Treatment of Cancer (EORTC) Study 22844. Int J Radiat Oncol Biol Phys 36, 1996
古い文献なのですが,ヨーロッパで低悪性度グリオーマ LGG 343例で前向き試験がなされました。 45 Gy (5 weeks) もしくは59.4 Gy (6.6 weeks)の照射がされましたが,74ヶ月の追跡期間で,全生存割合 OS にも無増悪生存割合 (PFS 47% vs. 50%) にも有意な差はありませんでした。
実例での治療方法の考え方:30代男性の限局性星細胞腫



2001年に無症状で偶然発見された右辺縁回の限局性星細胞腫 well-deliniated or localized astrocytomaと呼ばれるものです。非常に限局性で,T2で強い高信号になりT2-FLAIR mismatch signがあり,T1では低信号でガドリニウム増強されない典型的画像です。
腫瘍が発見されてから2年半で少し増大したので,開頭手術で全摘出 gross total removal しました。ドロドロの柔らかい腫瘍でしたから,その部分のみを摘出して,周囲の脳には手を付けませんでした。


発病後,5年目です。今度は,右前頭葉の深部白質に滲み込むように腫瘍再発しました。これを開頭手術でまた摘出してから,46グレイ23分割の放射線治療をしました。


その後には,外来でテモゾロマイド内服治療を24コース(2年間)行ないました。


左が再発から2年後,右が再発から8年後です。腫瘍の再増大はありません。FLLIRで高信号に見えるのは放射線治療の影響です。発見後すでに20年が経過したことになります。現在も無症状で腫瘍増悪なく技師として普通に社会人として生活しています。(この一連の画像は患者さんの許可を得て掲載しました。)
「コメント」右前頭葉の星細胞腫といえども,脳梁や前頭葉深部白質にかかっているものは,腫瘍の周りの脳も含めて摘出するということはできません。下にある画像は同じ患者さんの2020年のものです。上の方の画像は腫瘍のところばかり強調してみせたのですが,前頭葉の深部白質と脳梁膝部が温存された状態で治療が終了していることが解ると思います。だから社会生活ができるのです。


ナビゲーション,手術中MRI,覚醒下手術,ALAによる可視化などの技術を使って,もっと広範囲に脳を切除すれば,もしかすると手術だけで治った限局性星細胞腫だったかもしれません。でもこの腫瘍では,覚醒下手術で術中所見が出ることはないでしょうし,ALAでは浸潤部位の腫瘍が赤く光らなかったでしょうし,術中MRIをすれば摘出範囲をもう1cmくらい広げるべきだと考えたのかもしれません。しかし,それでは,前頭葉深部白質と脳梁膝部の損傷が生じていたのかもしれません。脳梁膝部を含めた広範囲切除は脳機能の低下を招くので,切除せずに放射線と化学療法で抑え込まなければ患者さんは社会生活を失います。
解剖学的に摘出できない位置にあるグリオーマは,覚醒下手術,ALA, 術中MRIなどを使っても摘出できないです。